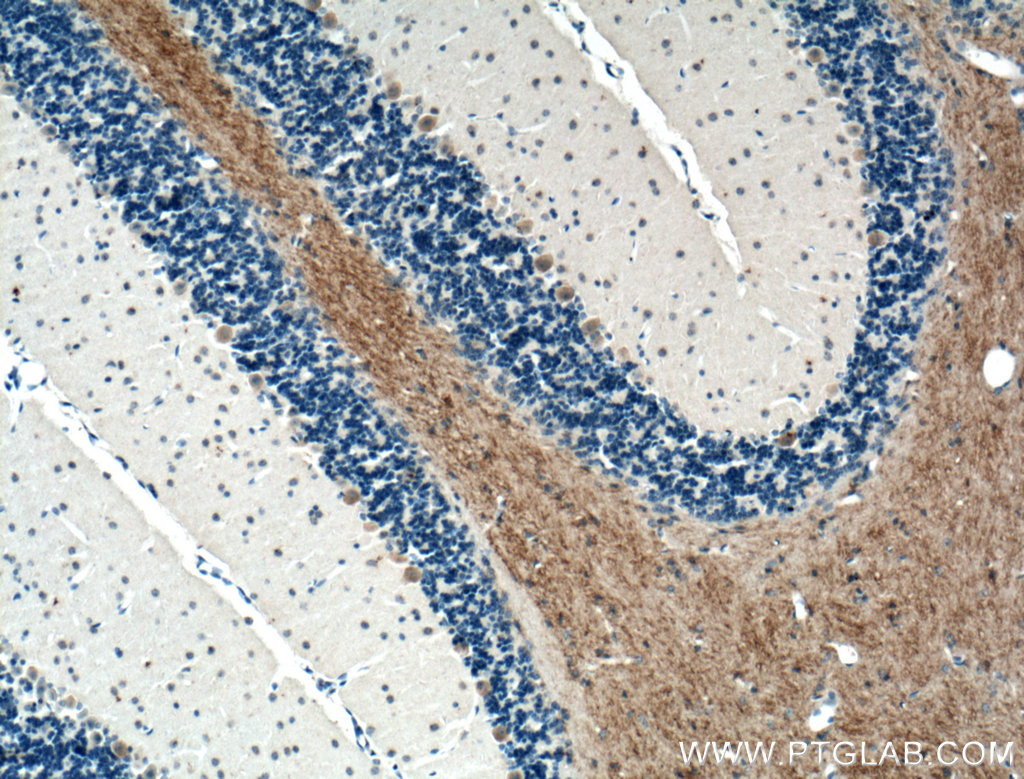

验证数据展示
经过测试的应用
| Positive WB detected in | mouse adipose tissue, mouse brain tissue, rat brain tissue |
| Positive IHC detected in | mouse skeletal muscle tissue, mouse cerebellum tissue, human heart tissue Note: suggested antigen retrieval with TE buffer pH 9.0; (*) Alternatively, antigen retrieval may be performed with citrate buffer pH 6.0 |
推荐稀释比
| 应用 | 推荐稀释比 |
|---|---|
| Western Blot (WB) | WB : 1:200-1:500 |
| Immunohistochemistry (IHC) | IHC : 1:50-1:500 |
| It is recommended that this reagent should be titrated in each testing system to obtain optimal results. | |
| Sample-dependent, Check data in validation data gallery. | |
发表文章中的应用
| IHC | See 2 publications below |
| IF | See 1 publications below |
产品信息
21048-1-AP targets GLUT4 in IHC, IF, ELISA applications and shows reactivity with human, mouse, rat samples.
| 经测试应用 | IHC, ELISA Application Description |
| 文献引用应用 | IHC, IF |
| 经测试反应性 | human, mouse, rat |
| 文献引用反应性 | human, mouse, rat, lasiopodomys brandtii |
| 免疫原 |
CatNo: Ag15390 Product name: Recombinant human GLUT4 protein Source: e coli.-derived, PGEX-4T Tag: GST Domain: 228-292 aa of BC069615 Sequence: RYLYIIQNLEGPARKSLKRLTGWADVSGVLAELKDEKRKLERERPLSLLQLLGSRTHRQPLIIAV 种属同源性预测 |
| 宿主/亚型 | Rabbit / IgG |
| 抗体类别 | Polyclonal |
| 产品类型 | Antibody |
| 全称 | solute carrier family 2 (facilitated glucose transporter), member 4 |
| 别名 | GLUT 4, GLUT4, SLC2A4 |
| 计算分子量 | 509 aa, 55 kDa |
| 观测分子量 | 50-55 kDa |
| GenBank蛋白编号 | BC069615 |
| 基因名称 | GLUT4 |
| Gene ID (NCBI) | 6517 |
| RRID | AB_2878802 |
| 偶联类型 | Unconjugated |
| 形式 | Liquid |
| 纯化方式 | Antigen affinity purification |
| UNIPROT ID | P14672 |
| 储存缓冲液 | PBS with 0.02% sodium azide and 50% glycerol, pH 7.3. |
| 储存条件 | Store at -20°C. Stable for one year after shipment. Aliquoting is unnecessary for -20oC storage. |
背景介绍
Glucose transporter 4 (GLUT4), also known as solute carrier family 2, facilitated glucose transporter member 4 (SLC2A4), is a transporter protein regulating glucose transport across cell membranes in an insulin-dependent manner.
What is the molecular weight of GLUT4? Is GLUT4 post-translationally modified?
The molecular weight of GLUT4 transporter is 55 kDa. GLUT4 can be N-glycosylated, which is important for its stability and trafficking between the recycling compartment and plasma membrane (PMID: 21757715 and 22545627), and it can also be ubiquitinated and phosphorylated (PMID: 23665900).
What is the subcellular localization of GLUT4?
Glucose transporters, including GLUT4, are multiple-pass integral membrane proteins. GLUT4 is present at the plasma membrane but is also a subject of recycling between plasma membrane and endosomes. The localization of GLUT4 depends on stimulation with insulin - in basal conditions GLUT4 is retained intracellularly, while upon insulin stimulation it is translocated to the plasma membrane (PMID: 18570632).
What molecules can be transported by GLUT4?
Although the main substrate of GLUT4 transport is glucose, it can also transport glucosamine.
What is the tissue expression pattern of GLUT4?
GLUT4 is expressed in white and brown adipose tissue and in muscle and heart cells, where it is the main glucose transporter responsible for peripheral glucose uptake in response to insulin.
Which cell lines can be used to study insulin-dependent GLUT4 protein translocation in glucose uptake assays?
Fat and muscle cells are primarily used in glucose uptake assays because they physiologically respond to insulin (PMID: 26646194). The most commonly used cell lines are 3T3-L1 cells (murine pre-adipose fibroblasts), L6 cells (rat myoblasts), and C2C12 cells (murine myoblasts).
发表文章
| Species | Application | Title |
|---|---|---|
Biomed Pharmacother Qing brick tea (QBT) aqueous extract protects monosodium glutamate-induced obese mice against metabolic syndrome and involves up-regulation Transcription Factor Nuclear Factor-Erythroid 2-Related Factor 2 (Nrf2) antioxidant pathway. | ||
J Hematol Oncol The PIK3CA E542K and E545K mutations promote glycolysis and proliferation via induction of the β-catenin/SIRT3 signaling pathway in cervical cancer. | ||
Development LONP1-mediated mitochondrial quality control safeguards metabolic shifts in heart development. | ||
Cell Physiol Biochem PGC-1α Participates in the Protective Effect of Chronic Intermittent Hypobaric Hypoxia on Cardiomyocytes. | ||
Food Chem Toxicol 3-Chloro-1, 2-propanediol inhibits autophagic flux by impairment of lysosomal function in HepG2 cells. | ||
J Cell Mol Med FGF19 protects skeletal muscle against obesity-induced muscle atrophy, metabolic derangement and abnormal irisin levels via the AMPK/SIRT-1/PGC-α pathway. |